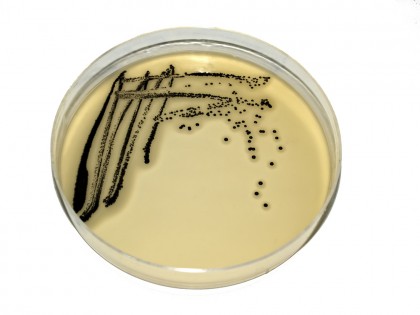

Lugdunin - un nou antibiotic care ar putea trata stafilococul
Cercetătorii din Germania au dezvoltat un nou antibiotic denumit Lugdunin care acționează împotriva unei tulpini bacteriene de Staphylococcus lugdunensis. Descoperirea a fost făcută în urma unei analize a bacteriilor de la nivelul cavității nazale a 90 de participanți la studiu.
Ulterior, cercetătorii au utilizat cu succes antibioticul împotriva MRSA (stafilococ auriu meticilino-rezistent) la șoareci. Totuși, antibioticul trebuie prelucrat astfel încât să fie eficient și la specia umană și acest lucru ar putea dura câțiva ani.
În mod normal, antibioticele sunt formate doar de bacteriile de la nivelul solului și de fungi. Recent s-a descoperit că microflora umană poate fi de asemenea o sursă de agenți antimicrobieni.
Cercetătorii au descoperit că tulpinile de MRSA și Staphylococcus lugdunensis se întâlnesc foarte rar împreună în cavitatea nazală umană, ceea ce înseamnă că Staphylococcus lugdunensis poate fi folosit pentru a combate MRSA.
Rezistența la antibiotice este o problemă serioasă a zilelelor noastre din cauza numărului în creștere al germenilor rezistenți. Se estimează că până în anul 2050, sute de morți vor fi cauzate de germenii rezistenți. Încă din 1980 nu s-a mai dezvoltat o clasă de antibiotice precum cea recent descoperită.
Există posibilitatea ca germenii rezistenți la antibioticele actuale să poată fi distruși de Lugdunin și orice altceva ce se găsește în cavitatea nazală.
Descoperirea a fost publicată în Nature.
Sursa: Science Alert
Copyright ROmedic: Articolul se află sub protecția drepturilor de autor. Reproducerea, chiar și parțială, este interzisă!
- Oamenii de știință spun că săpunurile antibacteriene sunt ineficiente și dăunătoare
- Vizitele regulate la dentist ar putea reduce riscul de pneumonie
- Vechi medicament pentru inimă, reutilizat pentru a ucide superbacteria spitalică Acinetobacter baumannii
- Un nou posibil tratament pentru infecţia cu rotavirus
- Stafilococ auriu hemolitic coagulazo pozitiv
- Este posibil sa aiba o tusa de 3-4 luni de la acest stafilococ?
- Tratamente pt stafilococ.
- Pot sa pastrez sarcina?
- Mi-au depistat stafilococ auriu - sotul meu trebuie sa faca tratament?
- Rinita incurabila?
- Stafilococ alb nepatogen
- Stafilococ coagulazo negativ
- Băiețelul meu de 4 luni are otita medie congestiva dreapta